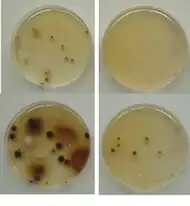

Kolloidales Silber
Kolloidales Silber (lateinisch argentum colloidale, von griech. kolla ‚leimartig‘) ist eine Verwendungsform von Silber. Es wurde medizinisch bis in die erste Hälfte des 20. Jahrhunderts zur Infektionsbekämpfung eingesetzt, als wirksamere Mittel wie Antibiotika und Antiseptika noch nicht zur Verfügung standen. Später trat es aber wegen damals zu hoher Herstellungskosten und Problemen bei der Herstellungsqualität in den Hintergrund. Eine medizinische Wirksamkeit oder ein gesundheitlicher Nutzen ist bei innerer Anwendung für keine der beanspruchten Anwendungen nachgewiesen.
Bei kolloidalem Silber handelt es sich um ultrafeine Partikel elementaren Silbers (Nanosilber) oder auch schwer löslicher Silberverbindungen bzw. deren flüssige Dispersionen. Für letztere werden synonym die Begriffe Silbersol und Silberwasser benutzt. Silberkolloiddispersionen bzw. Silbersole sind von Lösungen löslicher Silbersalze zu unterscheiden. Die Kolloidteilchen sind zwischen 1 und 100 nm groß[1] und weder mit dem Auge noch mit einem Lichtmikroskop erkennbar. In den einzelnen Teilchen sind etwa 1.000 bis 1 Milliarde Silberatome oder Moleküle der entsprechenden Silberverbindung enthalten. Im Gegensatz zu den Salzlösungen streuen Kolloide seitlich einfallendes Licht (Tyndall-Effekt) zum Beobachter.
Herstellung
Kolloidales Silber kann durch verschiedene Verfahren hergestellt werden:
- mechanisches Zermahlen in Kolloidmühlen
- elektrolytisch über verschiedene Verfahren
- rein chemische Verfahren (Reduktion von Silbersalzen, z. B. nass-chemisch,[2] sonochemisch[3])
Wirkung
Kolloidales Silber zeigt in vitro (d. h. außerhalb eines lebenden Organismus) eine antimikrobielle Wirkung und inaktiviert in bereits kleinen Konzentrationen eine Reihe von Bakterien und Pilzen.[5] Wirksames Agens sind dabei Silberkationen, die stets in kleinsten Mengen aus elementarem Silber oder auch aus schwerlöslichen Silberverbindungen freigesetzt werden und den Stoffwechsel von Mikroorganismen hemmen. Die minimale Hemmkonzentration (MHK) liegt bei circa 8 bis 100 ppm Silberionen,[6] grampositive Bakterien gelten als etwas empfindlicher als gramnegative.[6][7] Allerdings sind die Methoden für die Bestimmung der Suszeptibilität von Keimen gegenüber Silber bislang nicht ausreichend standardisiert. Die Hemmung kommt durch die Reaktion von Silberkationen mit schwefelhaltigen funktionellen Gruppen bestimmter Aminosäuren und Proteine zustande, welche dadurch inaktiviert werden. Dieser auch als oligodynamischer Effekt bezeichnete Wirkmechanismus ist nicht nur Silber zu eigen, sondern wird auch bei anderen Metallen beobachtet (z. B. bei Quecksilber, Kupfer, Zinn, Eisen, Blei, Bismut und Gold). Die Fähigkeit, gleichzeitig an verschiedenen Stellen im Zellstoffwechsel anzugreifen, erklärt das breite antimikrobielle Wirkspektrum von Silber und Silberverbindungen. Die Metallionen freisetzende Oberfläche ist bei Kolloiden besonders groß.
Die starke antimikrobielle Wirksamkeit von Nanosilber wird mit dessen Fähigkeit in Verbindung gebracht, Zellwände und Zellmembranen durchdringen zu können und im Zellinnern zu wirken.
In vitro wirkt kolloidales Silber auch gegen Viren, indem sich Nanosilberpartikel an deren Oberfläche binden und die Bindung der Viren an Wirtszellen unterdrücken.
Äußerliche Anwendung
Äußerlich wird kolloidales Silber aufgrund seiner antimikrobiellen Wirkung in kosmetischen Produkten wie Seifen, Cremes, Lotionen usw. verwendet. Der Sinn einer pflegenden Behandlung gesunder Haut mit Silber ist angesichts der lückenhaften Datenlage fragwürdig. Die Wirksamkeit in der therapiebegleitenden Pflege von atopischen Hauterkrankungen wurde in kleineren Studien und Anwendungsbeobachtungen untersucht.[5] Auch eine Reihe von Verbandsmaterialien und Wundauflagen ist mit kolloidalem Silber antibakteriell ausgestattet.
Für die medizinische Verwendung charakterisiert das Europäische Arzneibuch „Kolloidales Silber zum äußerlichen Gebrauch“, eine Silber-Eiweiß-Verbindung mit einem Gehalt von 70 bis 80 Prozent an elementarem Silber.[8]
Innerliche Anwendung
In der sogenannten Alternativmedizin werden Präparate mit kolloidalem Silber zum innerlichen Gebrauch als Allheilmittel für zahlreiche Anwendungsgebiete größtenteils über das Internet beworben, auch für lebensbedrohliche Krankheiten wie AIDS, Krebs, Diabetes und Tuberkulose.[9] Grundlage sollen hierfür eine antimikrobielle, aber auch weitere angebliche Wirkungen sein. Verschiedenste Produkte werden als „kolloidales Silber“, „Silberwasser“, „Silver Water“ (englisch) oder „Hunzawasser“ angeboten. Eine medizinische Wirksamkeit oder ein gesundheitlicher Nutzen ist für keine der beanspruchten Anwendungen nachgewiesen; stattdessen wird vor einer potentiellen Toxizität gewarnt.[9]
Von einer Verkehrsfähigkeit als Nahrungsergänzungsmittel ist für kolloidales Silber in Deutschland nicht auszugehen. Für Silber ist keine physiologische Funktion bekannt.[9] Nahrungsergänzungsmittel dürfen keinem therapeutischen Zweck dienen und auch nicht krankheitsbezogen beworben werden. Das Bundesinstitut für Arzneimittel und Medizinprodukte vertritt die Auffassung, dass Fertigpräparate mit kolloidalem Silber zum Einnehmen als Arzneimittel einzustufen seien.[10] Infolgedessen dürften sie gemäß arzneimittelrechtlichen Bestimmungen nur mit Erlaubnis hergestellt und nur mit einer entsprechenden Arzneimittelzulassung in den Verkehr gebracht werden. In der Vergangenheit sind Fälle von illegalem Vertrieb als Verstoß gegen das Arzneimittelgesetz geahndet worden.[11] Silberkolloide sind als alternativmedizinische, stark verdünnte Fertigarzneimittel, z. B. für die Homöopathie, legal vermarktbar.
In den USA stufte die FDA 1999 freiverkäufliche Arzneimittel sowohl für die innerliche als auch äußerliche Anwendung, die Silbersalze oder kolloidales Silber enthalten, als bedenklich ein, und es wurde eine eigene behördliche Verwaltungspraxis geschaffen.[12] In der Folge hat die Behörde mehrfach Firmen verwarnt hinsichtlich der unzulässigen Bewerbung von kolloidalem Silber zu antibiotischen oder anderen medizinischen Verwendungen.[13][14][15][16] Das National Center for Complementary and Alternative Medicine (NCCAM) der National Institutes of Health stellt in einem Faktenblatt die beobachteten Nebenwirkungen und Risiken sowie die fehlende Evidenz zu positiven Wirkungen auf die Gesundheit dar.[17]
Unerwünschte Wirkungen
Präparate mit hohem Silbergehalt können, besonders bei Verwendung über einen längeren Zeitraum hinweg, irreversible Silberablagerungen (Silberakkumulation) im Organismus verursachen, die u. a. zu Argyrie (Dunkelverfärbung der Haut), Argyrose (lokale Einlagerungen, insbesondere am Auge) und neurologischen Beeinträchtigungen führen können.[18][19][20] Auch in Gefäßen und inneren Organen wie Leber, Nieren, Milz und im Zentralnervensystem lagert sich Silber ab. Im Zusammenhang damit sind chronische Oberbauch-Schmerzen und zentralnervöse Erkrankungen wie Geschmacks- und Gangstörungen, Schwindel- oder Krampfanfälle beschrieben.[21]
Es bestehen Befürchtungen, dass ultrafeine Teilchen wie Nanopartikel, zu denen auch kolloidales Silber zählt, bei einer topischen Anwendung die Haut durchdringen und toxisch wirken könnten. Das Europäische Parlament hat dies durch eine Änderung der Verordnung (EG) Nr. 1223/2009 über kosmetische Mittel berücksichtigt. Zukünftig müssen Kosmetikhersteller Nanomaterialien in Kosmetika als solche deklarieren und außerdem die Ungefährlichkeit belegen.[22]
Einige Studien liefern Hinweise auf die Genotoxizität von Nanosilber. So liegen Hinweise auf DNA-Schädigungen vor, und nach subkutaner Injektion nanopartikulären Silbers wurde bei Ratten die Entstehung bösartiger Tumoren (Sarkomen) beobachtet.[23]:21
Insgesamt fehlen jedoch noch wissenschaftliche Erkenntnisse, welche den Behörden eine sachgerechte Einschätzung ermöglichen würden. Das Bundesministerium für Gesundheit resümiert: „für eine umfassende Risikoabschätzung von Nanosilber fehlt jedoch nach wie vor ausreichendes Datenmaterial – Schwellenwerte bzw. Dosis-Wirkungsbeziehungen sind nicht bekannt.“[23]:21 und warnt: „Eine großflächige und niedrig dosierte Anwendung von Nanosilber in Konsumprodukten könnte nach Ansicht von Fachleuten und wissenschaftlichen Beratungsgremien vielmehr die Entstehung von Allergien und die Selektion „multi-resistenter“ Krankheitserreger begünstigen. Damit droht die Gefahr, dass Silber nicht mehr als wichtige Waffe gegen pathogene Keime im medizinischen Bereich verfügbar wäre.“[23]:72 Dies sei für Experten vor allem deshalb problematisch, da eine positive Wirkung von Nanosilber in Konsumprodukten wie Kosmetika bislang nicht bewiesen wurde. Insgesamt ergebe sich damit im Bereich der Konsumprodukte eine erhöhte Risikolage, der kein ausgewiesener Nutzen gegenüberstehe.[23]:6,10,23,48
Resistenzbildung
Silberempfindliche Mikroorganismen können mit der Zeit silberresistent werden.[24] Über Plasmide kann der Resistenzmechanismus zwischen verschiedenen Bakterienarten ausgetauscht werden. Silberresistente Mikroorganismen wurden in Wasserfiltern nachgewiesen sowie bei Patienten mit Brandverletzungen, die mit silberhaltigen Mitteln behandelt wurden. Die klinische Bedeutung wird als bislang eher gering eingeschätzt.
Ökotoxikologie
Ob das ins Abwasser gelangte kolloidale Silber ökotoxikologische Auswirkungen für Kläranlagen und Gewässer hat, ist unklar. Früher nahm man an, es werde größtenteils in unlösliches Silbersulfid überführt, das im Klärschlamm an biologische Partikel gebunden sei.[25] Im Experiment bildete sich aber schwerlösliches Silberchlorid, auch wenn nur wenige Chlorid-Ionen in der Lösung vorhanden waren.[26]
Gesetzliche Regelungen
In Deutschland sind hinsichtlich der Produktabgrenzungsproblematik insbesondere das Arzneimittelgesetz, das Medizinproduktegesetz sowie das Lebensmittel-, Bedarfsgegenstände- und Futtermittelgesetzbuch und diverse diesem nachgeordnete Rechtsvorschriften (Kosmetik-Verordnung, Nahrungsergänzungsmittelverordnung) relevant.
Weblinks
- Sicherheit von Nanosilber in Verbraucherprodukten: Viele Fragen sind noch offen, BfR, 12. April 2011
- Bernd Kerschner: Unseriös: kolloidales Silber gegen Coronavirus, Bakterien & Co, Medizin transparent, 10. Mai 2021
- Josephine Görte: Kolloidales Silber – der harmlose Alleskönner?, MedWatch, 31. Januar 2022
- Science Cops: Die Akte Kolloidales Silber: Kolossaler Quatsch?, WDR/Quarks, 20. Januar 2023
Literatur
- I. Chopra: The increasing use of silver-based products as antimicrobial agents: a useful development or a cause for concern? In: J. Antimicrob. Chemother. 2007, doi:10.1093/jac/dkm006, PMID 17307768 (englisch).
- Gianluigi Franci et al.: Silver nanoparticles as potential antibacterial agents. In: Molecules. Band 20, Nr. 5, 18. Mai 2015, S. 8856–8874, doi:10.3390/molecules20058856, PMID 25993417 (englisch).
- Bund für Umwelt und Naturschutz Deutschland e. V. (Hrsg.): Nanosilber – Der Glanz täuscht. (bund.net [PDF; 583 kB; abgerufen am 2. Dezember 2009]).
Einzelnachweise
- ↑ H. Renner: Silber, Silber-Verbindungen und Silber-Legierungen. In: E. Bartholomé et al. (Hrsg.): Ullmanns Encyklopädie der technischen Chemie. Band 21, 4. Auflage, Verlag Chemie, Weinheim/New York 1982.
- ↑ Bahareh Khodashenas, Hamid Reza Ghorbani: Synthesis of silver nanoparticles with different shapes. In: Arabian Journal of Chemistry. Band 12, Nummer 8, 2019, S. 1823–1838, doi:10.1016/j.arabjc.2014.12.014. (freier Volltext) (Review)
- ↑ Green Sonochemical Route to Silver Nanoparticles. hielscher.com, abgerufen am 15. Februar 2016.
- ↑ Josef Pies, Uwe Reinelt: Kolloidales Silber. Das große Gesundheitsbuch für Mensch, Tier und Pflanze. 13. Auflage, VAK Verlag, Kirchzarten b. Freiburg 2019, ISBN 978-3-935767-85-9.
- ↑ a b R. Daniels et al.: Alte Aktivsubstanz in neuem Gewand. In: Pharmazeutische Zeitung. Ausgabe 16, 2009.
- ↑ a b Bundesinstitut für Risikobewertung: BfR rät von Nanosilber in Lebensmitteln und Produkten des täglichen Bedarfs ab (PDF; 84 kB). Stellungnahme Nr. 024/2010 vom 28. Dezember 2009.
- ↑ Müller, H.E: Untersuchungen zur oligodynamischen Wirkung von 17 verschiedenen Metallen auf Bacillus subtilis, Enterobacteriaceae, Legionellaceae, Mocrococcae und Pseudomonas aeruginosa. In: Zentralblatt für Bakteriologie, Mikrobiologie und Hygiene (B). Band 182, Nr. 1, 1985, S. 95–101. PMID 3939057
- ↑ Europäisches Arzneibuch. Monografie 6.0/2281.
- ↑ a b c Edzard Ernst: Heilung oder Humbug?: 150 alternativmedizinische Verfahren von Akupunktur bis Yoga. 1. Auflage. Springer, Berlin 2020, ISBN 978-3-662-61708-3, S. 144–145, doi:10.1007/978-3-662-61709-0.
- ↑ Stellungnahme des Bundesinstituts für Arzneimittel und Medizinprodukte (BfArM), wiedergegeben in der Sendung WISO des ZDF am 3. März 2008.
- ↑ Private Website von Edwin Blaschke ( vom 26. Juli 2010 im Internet Archive), einem ehemaligen Verkäufer von „Kolloidales Silber“.
- ↑ Code of Federal Regulations, Title 21, Volume 5. Revised as of April 1, 2010. Sec. 310.548: Drug products containing colloidal silver ingredients or silver salts offered over-the-counter (OTC) for the treatment and/or prevention of disease.
- ↑ FDA – Warning Letter: Natural Path / Silver Wings, LLC 4/25/11
- ↑ FDA: Wellness Resources ( vom 8. November 2011 im Internet Archive)
- ↑ FDA: Colloidal Silver Not Approved ( vom 30. Juni 2009 im Internet Archive)
- ↑ FDA – Warning Letter: EFT Inc 8/19/09
- ↑ National Center for Complementary and Alternative Medicine: Colloidal Silver Products, Mai 2004, abgerufen im August 2010.
- ↑ A. Wadhera et al.: Systemic argyria associated with ingestion of colloidal silver. In: Dermatol Online J. Band 1, Nr. 11, 2005, S. 12, PMID 15748553 (cdlib.org).
- ↑ A. L. Chang et al.: A case of argyria after colloidal silver ingestion. In: J Cutan Pathol. Band 33, Nr. 12, 2006, S. 809–811, PMID 17177941.
- ↑ Y. Kim et al.: A case of generalized argyria after ingestion of colloidal silver solution. In: Am J Ind Med. Band 52, Nr. 3, 2009, S. 246–250, PMID 19097083.
- ↑ A. Wadhera, M. Fung: Systemic argyria associated with ingestion of colloidal silver. In: Dermatol Online J. 11(1), 1. Mar 2005, S. 12. PMID 15748553
- ↑ Amtsblatt der Europäischen Union: Verordnung (EG) Nr. 1223/2009 des Europäischen Parlaments und des Rates vom 30. November 2009 über kosmetische Mittel (PDF).
- ↑ a b c d Nanosilber in Kosmetika, Hygieneartikeln und Lebensmittelkontaktmaterialien. Produkte, gesundheitliche und regulatorische Aspekte. ( vom 13. März 2013 im Internet Archive) (PDF; 1,3 MB), Bundesministerium für Gesundheit (Österreich), Februar 2010.
- ↑ Superkeime: Nicht genetische Resistenz gegen Nanosilber. Abgerufen am 28. Februar 2020.
- ↑ Bernd Schäfer et al.: State of the art in human risk assessment of silver compounds in consumer products: a conference report on silver and nanosilver held at the BfR in 2012. In: Archives of Toxicology. Band 87, Nr. 12, Dezember 2013, S. 2249–2262, doi:10.1007/s00204-013-1083-8, PMID 23779146, PMC 3841577 (freier Volltext).
- ↑ Kevin Wonner, Mathies V. Evers, Kristina Tschulik: Simultaneous Opto- and Spectro-Electrochemistry: Reactions of Individual Nanoparticles Uncovered by Dark-Field Microscopy. In: Journal of the American Chemical Society. 2018, doi:10.1021/jacs.8b02367.